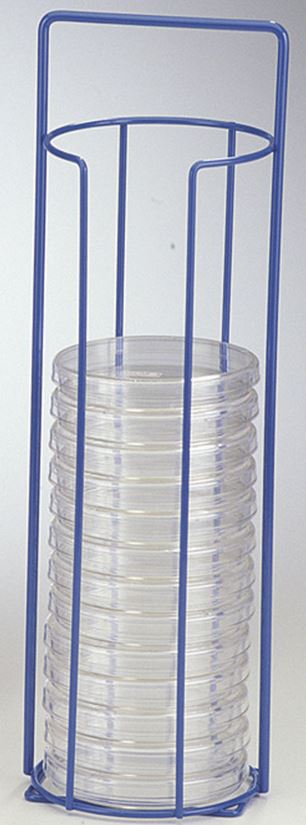
RACK for Petri-dish Ø 90mm, epoxy, single

RACK for Petri-dish Ø 90mm, epoxy, single
STD
ELABPEDI0RA2
Valid Article
Account code:
60200
HS Code:
901890
Last Updated on:
13/11/2025, 22:26:54
W05030380 - Microbiology devices - accessories
European Medical Device Nomenclature (EMDN) is the nomenclature of use by manufacturers when registering their medical devices in the EUDAMED database. EMDN is characterised by its alphanumeric structure that is established in a seven-level hierarchical tree.
(Petri-dish Ø 90mm) RACK
Definition
Rack to carry Petri dishes with 90 mm Ø.
Specifications
Material
Steel coated with epoxy
Technical specifications
- For Petri dishes with 90 et 100 mm Ø
- For 20 plates
- With handle for transporting
- Top loading
- Not suitable for glass Petri dishes
Dimensions
L x w x h: 108 x 108 x 356 mm
MSF requirements
To transport safely agar plates to and from the incubator.
Reserved for bacteriology programmes.
Some restricted information has been hidden. Sign in
to see this information

![[ELABPEDI1R90] PETRI DISH, plastic, sterile, Ø 90 mm](/web/image/product.template/572492/image_256/%5BELABPEDI1R90%5D%20PETRI%20DISH%2C%20plastic%2C%20sterile%2C%20%C3%98%2090%20mm?unique=0df4a5a)